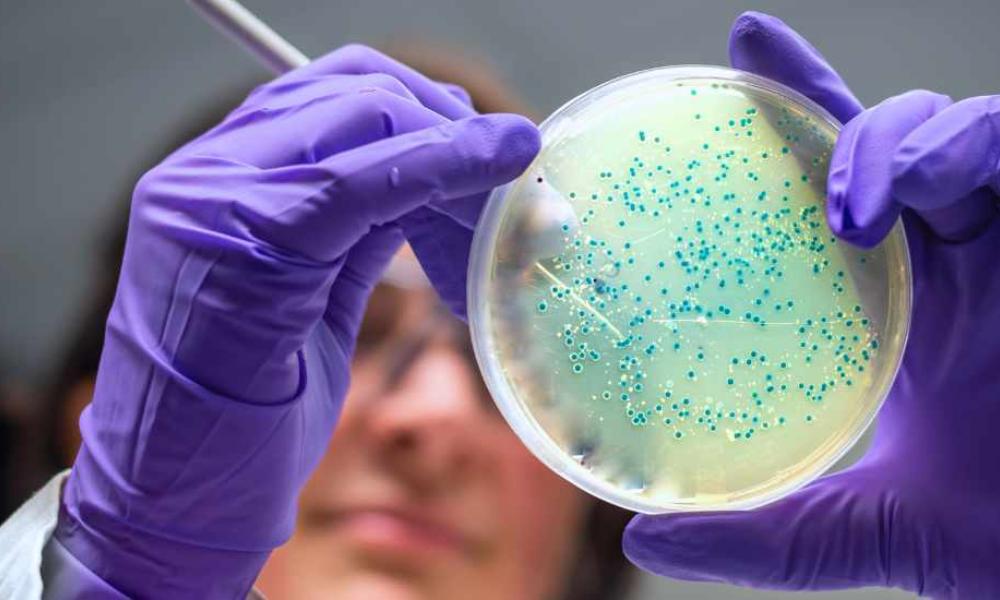
Ny EU-lov skærper kravene til Listeria-kontrol fra 2026 Ny EU-lov skærper kravene til Listeria-kontrol fra 2026

Bliv klogere
Type
Alle
ESG
Events og messer
Medarbejdere
Trends
Produkter
Alle
Blandinger og ompakninger
Emballage
Ingredienser
ProCera® ostevoks












.jpg&AlternativeImage=/Images/missing_image.jpg)